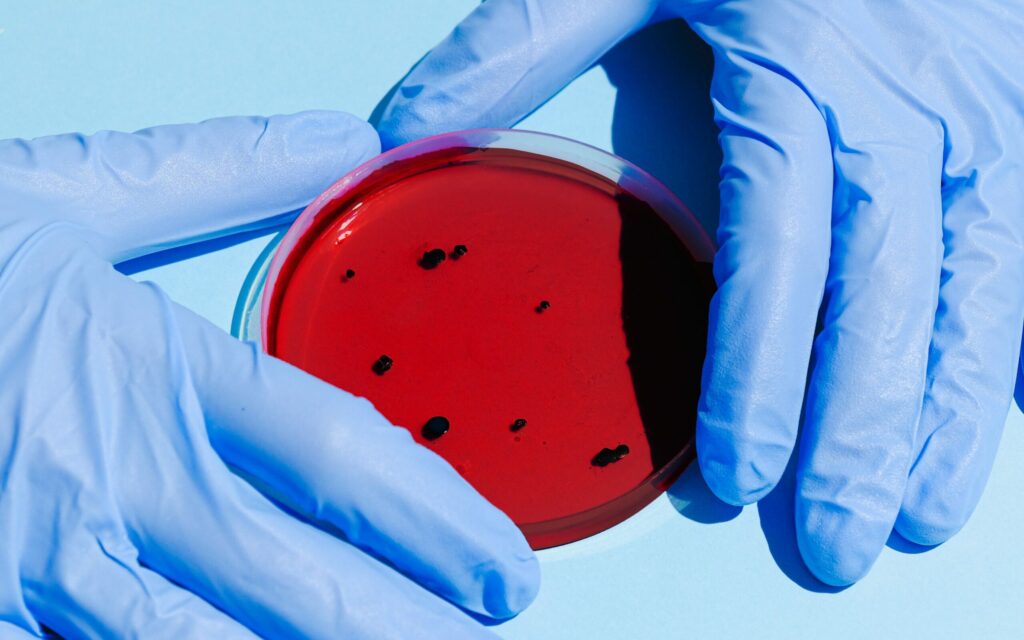

Jūlijā Latvijā konstatēts trešais pērtiķu baku gadījums, aģentūra LETA noskaidroja Slimību profilakses un kontroles centrā (SPKC).
Pēc SPKC pārstāves Ilzes Arājas paustā, 19.jūlijā Latvijā reģistrēts vēl viens pērtiķu baku inficētais. Arī šī persona, tāpat kā iepriekšējās divas, kurām slimību atklāja šī gada jūnija sākumā, inficējies ar pērtiķu bakām ārzemēs. Viņa informēja, ka pirmie divi slimošanas gadījumi ir noslēgušies. Visi līdz šim konstatētie gadījumi tiek epidemioloģiski uzraudzīti un noteiktas kontaktpersonas. SPKC nesaskata, ka Latvijā notiktu šīs infekcijas vietējā transmisija.
Jau ziņots, ka pērtiķu bakas ir reta vīrusu izraisīta infekcijas slimība, kura visbiežāk sastopama Centrālāfrikas un Rietumāfrikas valstīs. Infekcijas rezervuārs dabā joprojām nav zināms, bet vīruss tika konstatēts dažiem grauzējiem un pērtiķiem, no kuriem inficējās arī cilvēki. Pērtiķu baku gadījumi cilvēkiem bija reģistrēti arī ārpus Āfrikas saistībā ar starptautiskiem ceļojumiem vai importētiem dzīvniekiem.
Veselības jomas eksperti iepriekš bija norādījuši, ka vīrusam ir zema izplatība un viegla slimības gaita, tāpēc Latvijā nav nepieciešams nodrošināt masveida vakcināciju pret šo saslimšanu.
LETA